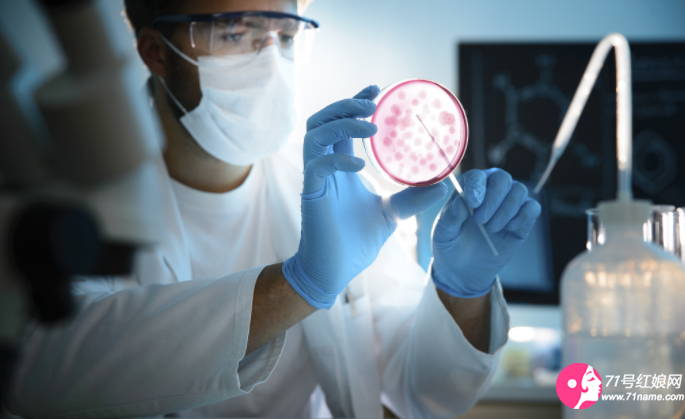
试管婴儿 试管婴儿

事情还得从几年前说起,李女士和丈夫是一对幸福的夫妻,然而多年没有要上孩子。经过医院多次治疗无果,确认李女士只能通过试管辅助生殖。经过2年半的时间,李女士在医院的试管辅助生殖技术帮助下顺利生下一子。在2020年9月,李女士的丈夫因头疼到医院就医,随后情况急转直下,40个小时左右被宣告死亡。此后李女士找到之前做胚胎移植手术的医院,希望医院能够帮助她实施手术,将仍在医院保存的剩余两个胚胎植入她体中。然而李女士没有想到,自己的诉求遭到医院的拒绝,于是将为她做试管婴儿的医院告上法庭。
如果医院为单身的李女士做了试管婴儿,这不仅是单身妇女做试管婴儿这么简单的事,因为亲生父亲去世了,又让其冷冻的精子生子,这涉及到严重的伦理问题,严重违背了千百年来的自然规律,应该需要法律严厉禁止。
福建分类征婚:
福州、厦门、泉州、漳州、石狮、三明、南平、莆田、永安、邵武、龙岩、福清、宁德
返回顶部